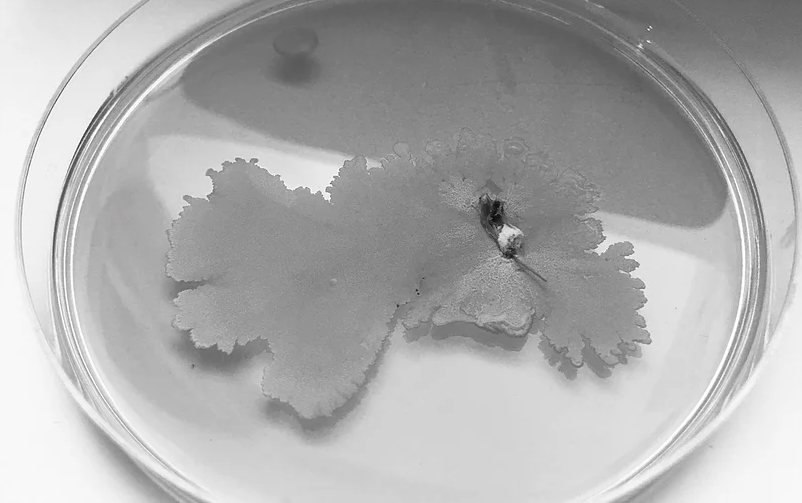

Роботы, грибы и природные умные системы в архитектуре
Катя Брыскина, архитектор, исследовательница и выпускница Института «Стрелка», прочитала лекцию о том, как изучение поведения муравьев, строения лобстера и состава мицелия помогает в работе с роботами и городским пространством. Лекция прошла в рамках недели Института «Стрелка» в Воронеже, мы ее записали и расшифровали.

Я работаю с новейшими технологиями в архитектуре: робототехникой, разработкой систем, которые созданы по образу и подобию биологических, занимаюсь выращиванием новых материалов и применяю это все для создания более крупных городских систем.
Сегодня мы воспринимаем город как «асфальтовые джунгли», взаимодействие машин и зданий, забывая о том, что это гораздо более сложная экосистема, в которой присутствует и природный слой. Зачастую он интегрирован в «рукотворный», и мы его просто не замечаем, хотя к нему можно отнести те же продукты питания и все то, что помогает поддерживать в городе жизнь. При этом скорость и масштабы городского строительства сегодня поражают воображение, а ведь строительный сектор ― один из самых опасных для экологии, потому что включает в себя не только процесс стройки как таковой, но и производство, логистику поставки и переработки материалов. Предстоит проделать огромную работу в этой области, чтобы как-то улучшить ситуацию. Однако сейчас я замечаю, что дизайнеры все чаще экспериментируют не только с разработкой продуктов, но и со способами их применения и разработки новых материалов. Периодически попадаются на глаза и коврики из пальм, и посуда из ферментированных бактерий, и это здорово, потому что эксперименты с материалом открывают новые возможности для дизайна. Наша задача ― учиться правильно их использовать.
На самом деле, искусственное ― это не так плохо, как звучит. Робототехнику зачастую также можно отнести к синтетическим системам, но вдохновленным миром органики: движения роботов и их взаимодействие друг с другом часто основаны на принципе роевых систем, так же ведут себя муравьи и многие другие маленькие насекомые. Природа предоставляет нам безлимитные возможности для вдохновения, какие принципы использовать. Я расскажу об этом на примере собственных проектов.
Я выпустилась из Архитектурной Ассоциации в Лондоне чуть больше двух лет назад, и моим дипломным проектом была разработка методики строительства крупных архитектурных объектов с помощью маленьких роботов. Сейчас много говорят о 3D-печати и ее возможностях, но, чтобы напечатать дом, нам не нужен большой принтер. Я подумала, что для этого можно было бы использовать простых роботов, каждый из которых выполнял бы определенную задачу в большой сложной системе.
В качестве рабочего материала была выбрана глина: нам было интересно поместить материал, используемый в строительстве на протяжении тысячелетий, в новый технологический контекст. Мы специально выбрали место, где глина ― локальный материал и все дома построены из нее, но при этом имеют ряд проблем, которые мы постарались пересмотреть.

В Гарварде ученые разработали систему, основанную на принципах поведения муравьев на их «стройке». Простые роботы запрограммированы, что делать, в зависимости от сигнала соседей. Если горит зеленая лампочка, робот присоединяется, красная ― продолжает движение. Их легко заменять, не нарушая при этом работу всей системы. Получается что-то вроде одного большого умного организма.
Наша же система состояла из четырех типов роботов. Первые печатали, вторые насыпали опалубку, которая необходима, чтобы не приходилось ждать, пока высохнет каждый слой, и была возможность строить в высоту. И так как у остается опалубка, мы печатали поверх нее, создавая соединяющий слой и интересное дизайн решение. Еще один тип ― роботы-станции, которые замешивают и подготавливают сам материал. В этой системе право разработки дизайна остается за человеком на основе ее возможностей, а задачи по его воплощению распределяются в системе автоматически. Печатать определенный отрезок едет тот робот, который заправлен и находится ближе всего. Вообще, самое интересное, что произошло за последние годы в сфере архитектуры, ― то, что мы теперь не просто рисуем что-то и заботимся только о конечном результате, а разрабатываем сам процесс, логику создания объекта.
Этот проект был сделан во время учебы в Архитектурной Ассоциации. Чем уникален лобстер? Если мы дотронемся до его панциря, то обнаружим, что какие-то части его жесткие, а
Мы разработали многослойную систему. Сначала нужно было натянуть латекс, а затем мы наклеивали на него паттерн из фанеры или других материалов, который деформировался по-разному в зависимости от его устройства и натяжения латекса. Мы провели большое количество тестов, совершенствуя процесс и улучшая цифровую модель. В результате мы разработали серию паттернов, которые помогали нам управлять общей формой.

Стартап Lium Labs ― это проект, занимающейся выращиванием биоматериалов из мицелия. Мицелий ― корневая система грибов, в которой содержится большое количество хитина: жесткость материала можно регулировать, увеличивая или уменьшая его количество. Важно не только то, что потенциальная сфера применения мицелия очень велика, но и то, что материалы из мицелия и растительных отходов могут расти буквально где угодно, не затрачивая к тому же на это большое количество энергии. Это помогло бы решить проблему транспортировки строительных материалов, о которой я говорила в начале.
В ходе тестов, которые мы провели, нам удалось получить разные текстуры и цвета: при недостатке воздуха спектр начинал меняться. Сейчас же мы больше думаем над формой и использованием мицелия в архитектуре. Большинство людей, державших материал в руках, говорят о необычных ощущениях: они чувствовали его природное происхождение, но в то же время видели, что он выращен не в природных условиях. То есть в нем соединились синтетическое и органическое направления.
Одну из наших инсталляций мы показали в начале лета на выставке в Новой Голландии в
Роботы и инсталляция из технической конопли
На воркшопе в «Стрелке», который прошел в рамках конференции «Архитектор будущего», мы использовали конопляный биокомпозит ― стружку из технической конопли мы смешали с гипсом в пропорции примерно 1:1, получая очень легкий материал. Хотя теоретически в качестве связующего вещества можно использовать и бетон. Участникам мы предоставили только исходные данные: есть вот такая смесь, есть насадки на роботов и метод производства ― два робота, которые могут растягивать и закручивать панели. Мы не предлагали концепцию дизайна и не разрабатывали ее заранее, решив дать возможность участникам попробовать и посмотреть, что получается.
Мы подготавливали смесь для биокомпозит и панели из него, а затем помещали их между двумя роботами. Мы протестировали несколько кодов-вариаций панелей участников, остановившись в итоге на одном, но панели все равно получались разными: иногда чуть отличалась смесь, иногда волокна ложились по-разному. Даже при технической точности не получалось до конца предсказать результат, и это тоже было интересно. Мы потом протестировали панели на прочность ― оказалось, что они способны выдержать до 20 кг.

Мицелий, гидропоника и новый синтетический ландшафт
Теперь я расскажу о более масштабном проекте, который я делаю с нашей студией IM-A studio. В его рамках мы исследуем, как деревья взаимодействуют между собой в естественных условиях и какую пользу из этого мы можем извлечь для городской среды.
Обычно в городе мы высаживаем деревья в ряд и думаем, что все отлично, напрочь забывая о необходимости создания связей между ними. Но, например, в лесу в тени большого дерева растут и набирают силу маленькие. Когда большое дерево умирает, оно отдает все свои микроэлементы этой системе, в которой мицелий служит связующим звеном. И после этого молодые деревья начинают активно расти. В городе же этого не происходит, растения существуют в неподходящей для них структуре и погибают гораздо раньше.
Мы начали разрабатывать новый синтетический ландшафт, где датчики считывают все необходимое для деревьев и растений, отслеживают все вплоть до влажности воздуха и того, как проходят процессы между ними. Мы их связываем в одну модульную систему, состоящую из четырех компонентов: гидропоники, водной системы, освещения и светодиодных датчиков.

Водная система является замкнутой, вода в ней циркулирует по кругу. Крупные растения растут в горшках, связанных между собой мицелиями, а травы хорошо себя чувствуют в блоке гидропоники. В системе есть разные спектры: красный и синий предназначены для растений, зеленый ― для людей. Каждая точка фасада модуля должна давать фидбек на фасаде, конвертируя био-импульсы в световые сигналы: синий говорит нам, что все в порядке, красный дает понять, что что-то не так. Также мы много экспериментировали с формой самой рамы, смотрели, как мы можем ее облегчить, как ускорить процесс ее сборки, что можем из этих модулей сконструировать. Гораздо проще обновить свой телефон, чем дом, в котором ты живешь. Поэтому на помощь должны прийти такие пластичные решения, которые «обвивают» эти здания или же становятся частью пространства.
Неделя Института «Стрелка» в Воронеже ― серия образовательных мероприятий о городской среде, проходивших с 9 по 12 октября в рамках программы социальных инвестиций «Формула хороших дел» при поддержке СИБУРа и департамента архитектуры и градостроительства Воронежской области.
